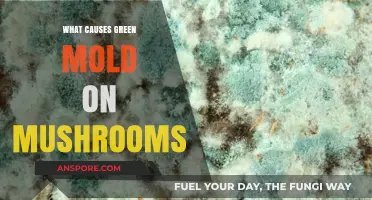
Understanding Green Mold on Mushrooms: Causes and Prevention Tips

Black mushrooms appearing in lawns are often the result of several environmental factors, primarily related to moisture, organic matter, and soil conditions. These fungi, typically species like *Coprinus comatus* (shaggy mane) or *Coprinopsis atramentaria*, thrive in damp, shady areas with rich organic debris, such as decaying wood, mulch, or thatch. Excessive watering, poor drainage, or over-mulching can create ideal conditions for their growth. Additionally, compacted soil or lawns with high nitrogen levels from fertilizers may encourage fungal development. While generally harmless to grass, black mushrooms can indicate underlying issues like overwatering or excessive thatch buildup, prompting homeowners to address these conditions to reduce their presence.
| Characteristics | Values |
|---|---|
| Cause | Decomposition of organic matter (e.g., wood, mulch, dead roots) |
| Fungal Type | Saprotrophic fungi (e.g., Coprinus comatus, Schizophyllum commune) |
| Appearance | Black or dark brown caps, often with gills or pores underneath |
| Size | Varies; typically 2–10 cm in diameter, depending on species |
| Growth Conditions | Moist, shady areas with high organic content in soil |
| Season | Most common in late summer and fall, but can appear year-round in mild climates |
| Impact on Lawn | Generally harmless to grass; indicates rich organic soil |
| Prevention | Reduce excess moisture, remove organic debris, and aerate soil |
| Removal | Pick by hand or use a fungicide if aesthetically undesirable |
| Benefits | Helps break down organic matter, improving soil health |
Explore related products
$20.65 $25.99
What You'll Learn
- Excessive moisture and poor drainage create ideal conditions for black mushrooms to grow
- Decaying organic matter, like wood or leaves, fuels mushroom growth in lawns
- Overwatering and shaded areas promote fungal development, including black mushrooms
- Soil rich in nutrients from compost or mulch can encourage mushroom formation
- Fungal spores spread through air, pets, or tools, leading to mushroom growth

Excessive moisture and poor drainage create ideal conditions for black mushrooms to grow
Black mushrooms in lawns are often a sign of underlying environmental conditions that favor fungal growth. One of the primary causes is excessive moisture and poor drainage, which creates an ideal habitat for these mushrooms to thrive. When a lawn retains too much water, either due to overwatering, heavy rainfall, or compacted soil, it becomes a breeding ground for fungi. Black mushrooms, in particular, are saprotrophic, meaning they feed on decaying organic matter, which is more abundant in wet environments. This excess moisture not only accelerates the decomposition process but also reduces oxygen levels in the soil, further encouraging fungal growth.
Poor drainage exacerbates the problem by allowing water to pool or remain in the soil for extended periods. Lawns with heavy clay soils, low-lying areas, or inadequate grading are especially susceptible. When water cannot drain properly, it creates a consistently damp environment that mushrooms find irresistible. Additionally, poor drainage can lead to waterlogged roots, weakening the grass and creating bare patches where mushrooms can easily take hold. Addressing drainage issues is therefore critical in preventing black mushrooms from appearing in the first place.
To combat excessive moisture, it’s essential to adjust watering practices. Avoid overwatering your lawn, and ensure irrigation systems are functioning correctly to prevent waterlogging. Water deeply but infrequently to encourage deep root growth, which helps grass withstand dry periods and reduces surface moisture. For areas prone to standing water, consider installing drainage solutions such as French drains, dry wells, or regrading the lawn to slope away from problem areas. These measures will help water move away from the lawn efficiently, reducing the damp conditions that mushrooms require.
Improving soil structure is another effective way to mitigate poor drainage and excess moisture. Aerating compacted soil allows water to penetrate more easily and encourages better airflow, which discourages fungal growth. Incorporating organic matter, such as compost, into the soil can also improve its ability to retain the right balance of moisture without becoming waterlogged. For clay-heavy soils, adding sand or other amendments can enhance drainage and prevent water from pooling.
Finally, maintaining a healthy lawn is key to preventing black mushrooms. Strong, dense grass outcompetes fungi for resources and leaves less room for mushrooms to grow. Regular mowing, proper fertilization, and weed control contribute to overall lawn health. If mushrooms do appear, manually removing them can help prevent spore dispersal, but addressing the root cause—excessive moisture and poor drainage—is the most effective long-term solution. By creating an environment less favorable to fungal growth, you can keep your lawn mushroom-free and thriving.
Do Tree House Mushroom Bars Contain THC? Facts Revealed
You may want to see also

Decaying organic matter, like wood or leaves, fuels mushroom growth in lawns
Decaying organic matter, such as wood or leaves, serves as a primary food source for mushrooms, making it a significant factor in their growth in lawns. When organic materials break down, they release nutrients like nitrogen, carbon, and other essential elements that fungi, including mushrooms, thrive on. This process is particularly common in areas where tree stumps, buried wood, or thick layers of fallen leaves are present. Over time, these materials decompose, creating an ideal environment for mushroom mycelium—the vegetative part of the fungus—to develop and eventually produce visible fruiting bodies, which are the mushrooms themselves.
Lawns with a history of tree removal or those located near wooded areas are especially prone to mushroom growth fueled by decaying organic matter. Tree stumps and roots left in the ground continue to decompose, providing a long-term nutrient source for fungi. Similarly, leaves that are not regularly raked or mulched can form dense mats, trapping moisture and creating a perfect breeding ground for mushrooms. Homeowners often notice mushrooms appearing in these spots, particularly after periods of rain, as moisture accelerates the decomposition process and stimulates fungal activity.
Addressing mushroom growth in lawns requires targeting the underlying decaying organic matter. One effective method is to remove or grind down tree stumps and roots to eliminate their nutrient contribution. For leaf litter, regular raking, mulching, or composting can prevent the buildup of organic material that mushrooms rely on. Additionally, improving lawn aeration and drainage can discourage the damp, humid conditions that fungi favor. By reducing the availability of decaying matter, you can significantly minimize mushroom growth and maintain a healthier lawn.
It’s important to note that while mushrooms themselves are not harmful to grass, their presence indicates an ecosystem at work beneath the surface. Decaying organic matter enriches the soil, but excessive accumulation can lead to unwanted fungal growth. Striking a balance by managing organic debris while allowing natural decomposition processes to occur is key. For example, leaving thin layers of mulched leaves can benefit the soil without fostering mushroom proliferation. Understanding this dynamic helps homeowners take proactive steps to control mushroom growth while supporting overall lawn health.
In cases where mushrooms persist despite efforts to remove decaying matter, it may be necessary to investigate other potential causes, such as buried wood debris or compost mixed into the soil. Sometimes, construction or landscaping activities inadvertently introduce organic material into the lawn, creating hidden fuel sources for fungi. Conducting a thorough inspection of the affected area and addressing any overlooked organic matter can provide a long-term solution to mushroom growth. By focusing on the root cause—decaying organic matter—homeowners can effectively manage black mushrooms in their lawns.
Chewing Magic Mushrooms: Does It Make Them Work Faster?
You may want to see also

Overwatering and shaded areas promote fungal development, including black mushrooms
Black mushrooms in lawns are often a sign of underlying environmental conditions that favor fungal growth. One of the primary culprits is overwatering, which creates a consistently moist environment that fungi thrive in. When lawns are watered excessively, the soil retains more moisture than necessary, depriving grassroots of oxygen and weakening their ability to resist fungal invaders. This damp condition not only encourages the growth of black mushrooms but also other types of fungi. To mitigate this, it’s essential to adopt a water-efficient irrigation schedule, ensuring the lawn receives only the amount of water it needs, typically 1 to 1.5 inches per week, including rainfall. Water deeply but infrequently to encourage deep root growth and reduce surface moisture.
In addition to overwatering, shaded areas in lawns significantly contribute to the development of black mushrooms. Shaded spots receive less sunlight, which slows the evaporation of moisture from the soil and plant surfaces. This prolonged dampness creates an ideal habitat for fungi to flourish. Trees, shrubs, or structures that block sunlight can exacerbate this issue, especially in regions with high humidity. To address this, consider pruning overgrown vegetation to allow more sunlight to reach the lawn. If shading is unavoidable, it may be necessary to improve air circulation by thinning out dense plantings or using shade-tolerant grass species that require less sunlight.
The combination of overwatering and shaded areas creates a perfect storm for fungal development, including black mushrooms. Fungi are opportunistic organisms that capitalize on weak or stressed grass, which often results from these conditions. When grass is constantly wet and lacks sunlight, its growth slows, and its natural defenses weaken, making it more susceptible to fungal colonization. Regularly inspect shaded and frequently wet areas of your lawn for early signs of fungal activity, such as discolored patches or mushroom growth. Addressing these issues promptly can prevent the spread of fungi and maintain a healthier lawn.
To further discourage black mushrooms, focus on improving soil health in overwatered and shaded areas. Compact soil retains more water and restricts root growth, so aerating the lawn can help reduce moisture buildup and improve drainage. Additionally, applying organic matter, such as compost, can enhance soil structure and promote beneficial microbial activity that competes with fungi. Avoid using excessive nitrogen-rich fertilizers, as they can stimulate rapid, weak grass growth that is more prone to fungal infections. Instead, opt for balanced fertilizers applied according to seasonal needs.
Finally, cultural practices play a crucial role in preventing fungal development. Remove black mushrooms manually as soon as they appear to prevent spore dispersal, which can lead to further growth. Dispose of the mushrooms in sealed bags to avoid spreading spores. In heavily shaded areas where grass struggles to grow, consider alternatives such as shade-tolerant ground covers or mulch to reduce fungal habitats. By addressing overwatering, managing shade, and maintaining overall lawn health, you can significantly reduce the occurrence of black mushrooms and create an environment less hospitable to fungi.
Mushrooms and Digestion: Are They Gentle on Your Stomach?
You may want to see also
Explore related products

Soil rich in nutrients from compost or mulch can encourage mushroom formation
Soil rich in nutrients from compost or mulch can indeed encourage mushroom formation, particularly the black mushrooms often found in lawns. Mushrooms are the fruiting bodies of fungi, which thrive in environments with abundant organic matter. When you add compost or mulch to your lawn, you introduce a wealth of nutrients such as nitrogen, phosphorus, and potassium, which are essential for fungal growth. These materials also improve soil structure, retaining moisture and creating a humid environment that fungi favor. While compost and mulch are beneficial for plant health, they inadvertently create ideal conditions for mushrooms to flourish.
The decomposition process of organic matter in compost or mulch generates warmth and releases nutrients gradually, providing a steady food source for fungi. Black mushrooms, in particular, are often associated with wood-decomposing fungi, which break down lignin and cellulose found in mulch or decaying plant material. If your mulch contains wood chips or bark, it can serve as both a nutrient source and a substrate for these fungi to grow. Over time, as the fungi colonize the soil, they produce mushrooms as part of their reproductive cycle, leading to their appearance on your lawn.
To manage mushroom growth in nutrient-rich soil, it’s important to strike a balance between soil fertility and fungal activity. While reducing the amount of compost or mulch can help, it may not be practical if you rely on these materials for soil health. Instead, consider aerating your lawn to reduce soil compaction and improve drainage, as fungi thrive in waterlogged conditions. Additionally, raking or removing mushrooms as they appear can prevent spore dispersal, which could otherwise lead to more fungal growth. However, it’s crucial to remember that mushrooms are a natural part of a healthy ecosystem and often indicate that your soil is rich in organic matter.
If the presence of black mushrooms is a concern, examine the type of mulch or compost you’re using. Opt for well-aged compost or mulch that has fully decomposed, as it is less likely to harbor active fungal colonies. Avoid piling mulch too deeply around plants, as excessive layers can create a breeding ground for fungi. Regularly turning compost piles can also help accelerate decomposition and reduce the likelihood of fungal growth. By managing the application and type of organic matter, you can maintain a nutrient-rich soil while minimizing unwanted mushroom formation.
Ultimately, soil rich in nutrients from compost or mulch is a double-edged sword when it comes to mushrooms. While it promotes plant growth and soil health, it also provides the perfect habitat for fungi to thrive. Black mushrooms in your lawn are a sign of a thriving fungal network, which plays a vital role in nutrient cycling and soil structure. Rather than eliminating them entirely, focus on managing their growth through thoughtful lawn care practices. Embrace the presence of mushrooms as an indicator of a healthy, vibrant soil ecosystem, and take steps to ensure they don’t become a nuisance.
Mushrooms' Survival Secrets: A Natural Mystery
You may want to see also

Fungal spores spread through air, pets, or tools, leading to mushroom growth
Fungal spores are a primary cause of black mushrooms appearing in lawns, and their spread is facilitated through various means, including air, pets, and tools. These spores are microscopic and lightweight, allowing them to travel significant distances through the air, especially during windy conditions or when disturbed by lawn maintenance activities. Once airborne, they can settle on grass, soil, or other organic matter, where they germinate under suitable conditions of moisture and temperature. This natural dispersal mechanism ensures that fungal spores can colonize new areas, leading to mushroom growth in seemingly unaffected parts of the lawn.
Pets, particularly dogs, play a significant role in the spread of fungal spores. As pets roam through the lawn, spores can adhere to their fur, paws, or even be ingested and later deposited in feces. When pets move from one area to another, they inadvertently carry these spores, introducing them to new locations. Additionally, pets may dig or disturb the soil, exposing buried spores and creating favorable conditions for mushroom growth. Regularly cleaning pet paws and grooming them can help minimize the spread of spores, but it’s challenging to eliminate this pathway entirely.
Garden tools and equipment are another common vector for fungal spore dispersal. When tools like rakes, shovels, or lawnmowers are used in areas where mushrooms are present, spores can cling to the surfaces of these tools. If the same tools are then used in other parts of the lawn, they transfer the spores, potentially leading to new mushroom colonies. To mitigate this, it’s essential to clean and disinfect tools after use, especially when working in areas with visible mushrooms. This practice reduces the risk of inadvertently spreading spores across the lawn.
The presence of organic matter, such as decaying wood, leaves, or thatch, provides an ideal environment for fungal spores to thrive. As these materials decompose, they release nutrients that fungi need to grow, and the spores present in the air or soil can quickly colonize these areas. Mushrooms often appear in lawns with excessive thatch or where trees or stumps have been removed, as the remaining organic debris supports fungal growth. Regular lawn maintenance, including dethatching and removing debris, can help reduce the availability of these substrates and limit mushroom development.
Finally, environmental conditions play a crucial role in the germination and growth of fungal spores. Moist, shaded areas with poor air circulation are particularly conducive to mushroom growth. Overwatering or poor drainage can create persistently damp conditions that encourage spore germination. To discourage mushroom growth, ensure proper lawn drainage, avoid overwatering, and trim back overhanging branches to increase sunlight and airflow. While it’s impossible to completely eliminate fungal spores from the environment, managing these factors can significantly reduce the likelihood of black mushrooms appearing in your lawn.
Recognizing Hallucinogenic Mushrooms: A Guide
You may want to see also
Frequently asked questions
Black mushrooms in lawns are typically caused by decaying organic matter, such as dead roots, wood, or mulch, combined with moist soil conditions. Fungi thrive in these environments, leading to mushroom growth.
While many black mushrooms are not toxic, some species can be poisonous. It’s best to avoid touching or ingesting them and to keep pets and children away. If ingestion occurs, seek medical or veterinary advice immediately.
Reduce moisture by improving drainage and avoiding overwatering. Remove decaying organic material, aerate the soil, and maintain a healthy lawn to discourage fungal growth. Fungicides may also help in severe cases.
Black mushrooms often signal excess moisture or organic debris in the soil. While they don’t directly harm grass, they may indicate poor drainage or overwatering, which can lead to other lawn issues if not addressed.